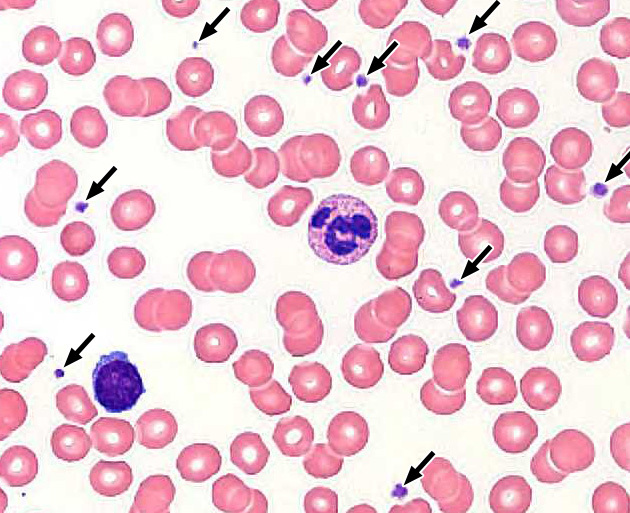
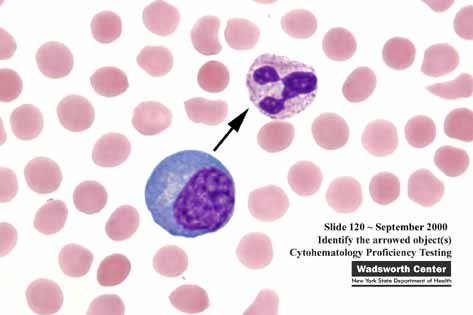
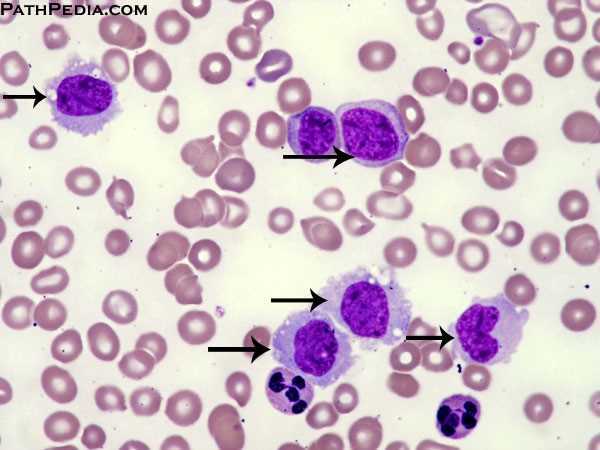
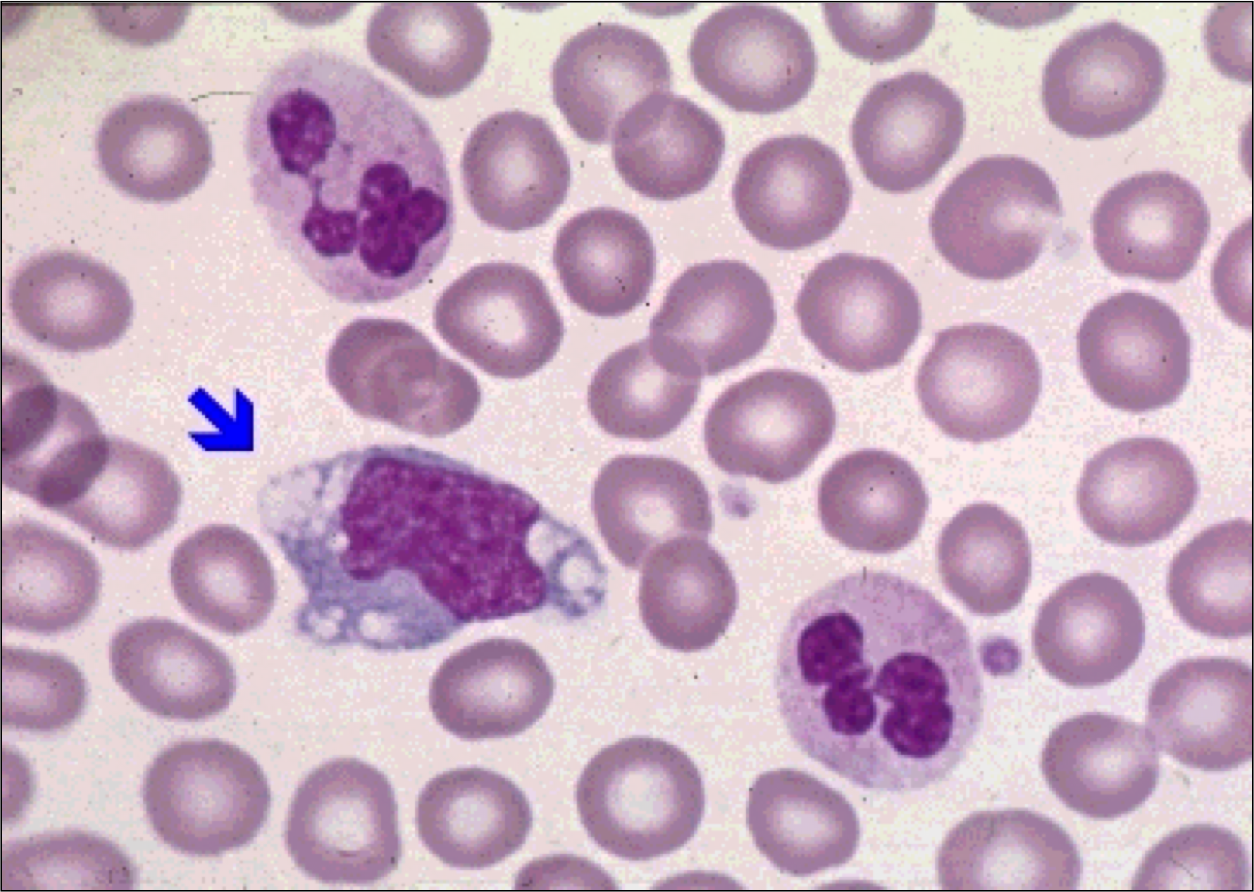

what are these?

erythrocytes
life span of erythrocytes?
120 days
which cell has HCO3/Cl antiporter in membrane?
RBC - allows export of HCO3 and transport of CO2 to lungs
what are these? (arrows)
platelets
lifespan of platelets?
8-10 days
what is in dense granules? what cells have dense granules?
contents: ADP, Ca
in platelets
what is in alpha granules? what cells have alpha granules?
vWF, fibrinogen
in platelets
what are the vWF and fibrinogen receptors?
vWF: GP Ib
fibrinogen: GP IIb/IIIa
WBC differential from highest to lowest?
Neutrophils Like Making Everything Better
neutrophils
lymphocytes
monocytes
eosinophils
basophils
what kind of cell is this? (arrow)
neutrophil: multilobed nucleus
what is in specific granules? what cell has specific granules?
ALP, collagenase, lysozyme, lactoferrin
in neutrophils
what is in azurophilic granules? what cell has azurophilic granules?
proteinases, acid phosphatase, myeloperoxidase, beta-glucuronidase
in neutrophils
when do you see bandemia?
myeloid proliferation: bacterial infection, CML
what are neutrophil chemotactic agents?
C5a, IL8, LTB4, kallikrein, platelet-activating factor
what kind of cells are these? (arrows)
monocytes
large kidney shaped nucleus
frosted-glass cytoplasm
what kind of cell is this? (arrow)
macrophage
where do macrophages come from?
monocytes; activated by IFN-gamma
which cell has CD14 and what does it do?
macrophage
lipid A (LPS) binds CD14 –> septic shock
what kinds of cells are these (short fat arrows)?

eosinophils (bilobate nucleus, eosinophilic granules)
what do eosinophils produce?
histaminase
major basic protein (kills helminths)
what are causes of eosinophila?
NAACP
neoplasia
asthma
allergic processes
chronic adrenal insufficiency
parasites
what kinds of cells are these (long skinny arrows)?

basophils
basophilic granules
what are in basophil granules?
heparain and histamine
leukotrienes synthesized on demand
when do you see basophilia?
CML